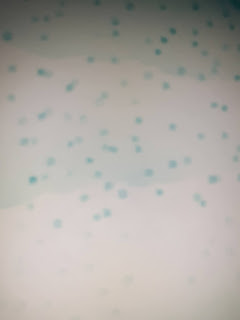

Bonjour et bienvenue
Je suis vraiment dans le "Christmas Vibe" en ce moment. J'aime aller de l'avant, pour que toutes les cartes soient faites longtemps à l'avance.
La carte d'aujourd'hui est idéale pour la production en masse, car vous pouvez découper de nombreuses maisons à partir de nombreux papiers cartonnés différents et en ajouter ou plus à votre projet.
Des produits
Matrice de découpe Home for the Holidays Stacks (Concord et 9e)
Accueil pour les vacances Piles de timbres (Concorde et 9e)
https://www.bumbleberrys.co.uk/collections/concord-9th/products/home-for-the-holidays-stacks-3x4-c9
Mélangez et associez les sentiments des fêtes (Concord et 9e)
Matrices de découpe Mélangez et assortissez les sentiments des Fêtes (Concord et 9e)
(C'est un reste d'une autre marque, je l'ai donc ajouté à ce design)
Papier cartonné
Minuit, Evergreen, Cranberry et Stardust (Concord & 9th)
Tampons encreurs
Minuit, Oceanside, Cranberry, Aqua Sky (Concord et 9e)
Stylo scintillant (Spectrum Noir)
Carte vierge 5 x 7 pouces
Méthode
Tout d’abord, prenez votre carte vierge et posez-la prête à travailler. Déchirez ensuite un morceau de papier pour créer des congères (de minuscules collines).
J'ai commencé avec l'encre aquarelle pour les congères et j'ai remonté la carte. Une fois en haut, j'ajoute l'encre Oceanside sur le bord de la carte. Apportez le ton plus sombre. J'ai utilisé la couleur d'encre Midnight pour le ciel nocturne.
En utilisant l'encre plus claire, l'aqua, je tamponne le motif à pois avec de l'encre de première et deuxième génération pour créer de la neige.
La dernière étape de l'arrière-plan était un stylo scintillant que j'ai passé sur les lecteurs de neige en me concentrant davantage sur le haut de la carte.
Cela a ensuite été laissé sécher, pourquoi je suis mort en coupant les maisons, les arbres, etc...